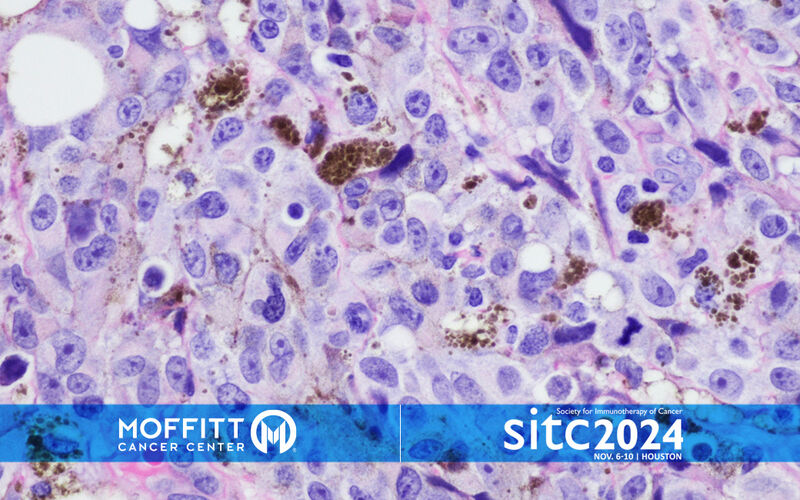

Moffitt Experts Share Discoveries Driving Innovation in Cancer Immunotherapy
Immunotherapy is an innovative cancer treatment that harnesses the immune system to fight cancer. This can be done by stimulating a patient’s immune system to target cancer cells or by introducing human-made elements into the body. There are several types of immunotherapy treatments, including chimeric antigen T-cell therapy (CAR T), tumor-infiltrating lymphocyte therapy (TIL) and cancer vaccines.
Immunotherapy has changed the course of cancer treatment, and research continues every day to improve current therapies and discover new ones. Every year, leaders from academia, industry and health care convene at the Society for Immunotherapy of Cancer annual meeting to shape the future of cancer treatment through immunotherapy. With more than 1,500 abstracts submitted, the conference highlights cutting-edge research on immune-based therapies, including cellular treatments, novel checkpoint inhibitors and combination strategies aimed at improving patient outcomes.
In addition to research presentations, the 2024 Society for Immunotherapy of Cancer annual meeting provides updates on significant international initiatives, industry-academic collaborations and society-led projects to accelerate the integration of immunotherapies into clinical practice. Attendees have opportunities to network and discuss the practical application of these innovations, with sessions on biomarker-driven treatment approaches and cost-effectiveness insights.
Moffitt Cancer Center is well represented this year, contributing a dozen preconference workshop presentations and over 30 presentations during the main conference. To learn more about Moffitt’s presentations at the meeting, click here and read the stories below.
Moffitt Cancer Center is excited about the 2024 Society for Immunotherapy of Cancer Annual Meeting! As leaders of immunotherapy, we look forward to highlighting dozens of our researchers and sharing how Moffitt is impacting cancer outcomes.
— Moffitt Cancer Center (@MoffittNews) November 6, 2024
Stay tuned for updates with… pic.twitter.com/kguA8XdLFh